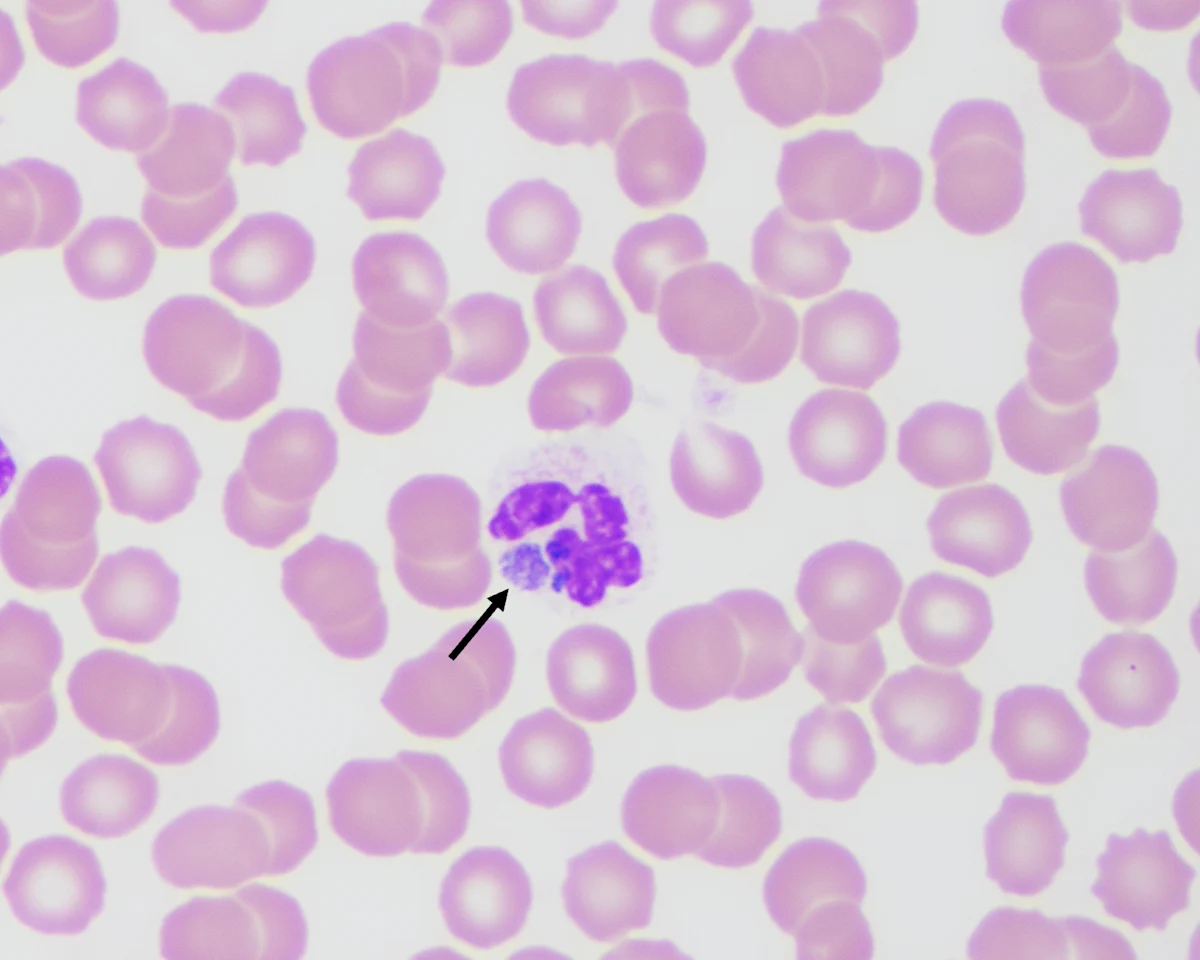
Arrow pointing to a round, purple-stained organism within cytoplasm of a neutrophil surrounded by red blood cells.
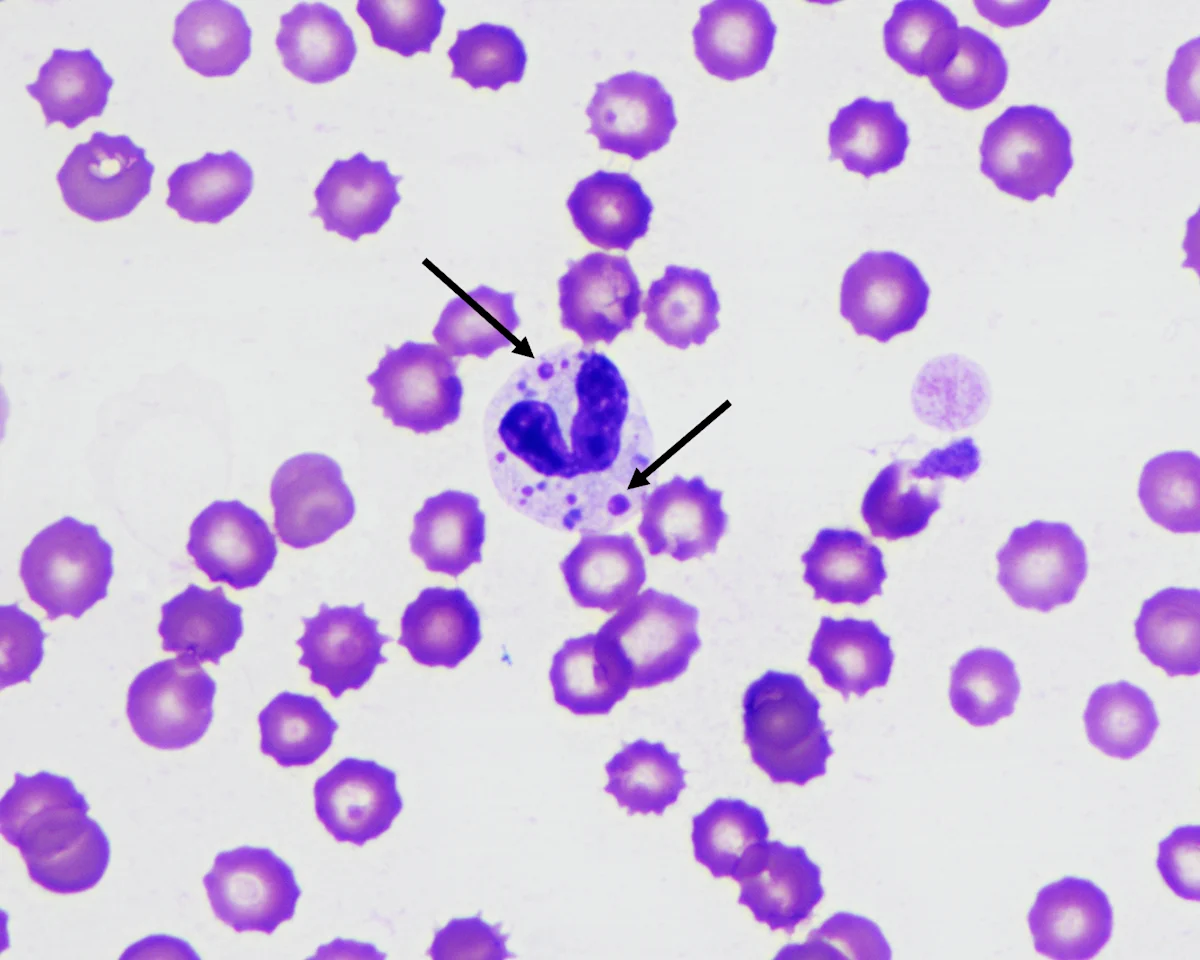
Arrows pointing to multiple purple, round organisms of variable size located within the cytoplasm of a neutrophil.

Wright-Giemsa stain; 100× oil objective
Affordable, effective diagnostics can provide access to care and are increasingly important in veterinary medicine. Microscopic examination of cytologic and blood smear specimens provides an inexpensive, quick, easy, and minimally invasive method for diagnosis of infectious disease in most practice settings and can be helpful in making a presumptive or definitive diagnosis of many bacterial, fungal, viral, protozoal, and parasitic infections. Identification of infectious disease agents on cytology can lead to early diagnosis and treatment, improving patient outcomes.
Information from cytology and blood smears should always be correlated with patient history, physical examination findings, and diagnostic and imaging results. A high-quality specimen is critical for maximizing the diagnostic yield of cytology and blood smears. Methods for acquiring and reviewing high-quality cytologic and blood smear specimens are described in the literature.1,2
Absence of visible infectious agents on cytology does not rule out infectious etiologies, and many infectious agents in veterinary patients are zoonotic, highlighting the need for consistent, appropriate use of personal protective equipment when acquiring and handling specimens.
Many infectious agents require additional testing (eg, culture, PCR assay) to confirm diagnosis. If an infectious etiology is suspected based on cytologic results or examination of a blood smear, the stained samples and additional unstained samples should be sent to a clinical pathologist. Providing complete patient information (eg, signalment, clinical history, medication history) and a full description of the sampled lesion or mass (eg, size, location, duration, shape, texture, appearance) are important when submitting slides to a diagnostic laboratory.
The following images show bacterial, fungal, viral, protozoal, and parasitic infectious agents that can be identified on examination of cytologic and blood smear specimens.
Blastomyces dermatitidis

Wright-Giemsa stain; 100× oil objective
FIGURE 1 An impression smear obtained from a nonhealing wound on the dorsum of a 1-year-old female coonhound dog. The dermal lesion was slightly firm, ulcerated, swollen, and movable and produced an exudative discharge. Cytology revealed marked mixed (macrophagic and neutrophilic) inflammation with rare, deeply basophilic, thick-walled, round, extracellular yeast structures measuring 10 to 15 µm in diameter, characteristic of Blastomyces dermatitidis (arrow). The yeast occasionally exhibited broad-based budding and were often surrounded by neutrophils (arrowhead).
Identification of Blastomyces spp yeast in cytologic or histopathologic specimens from affected tissues remains the best practice for diagnosis of Blastomyces spp infection.3 In cases in which diagnosis is suspected but cannot be confirmed, additional diagnostics (eg, urine fungal antigen testing via quantitative enzyme immunoassay) can be helpful.
Mycoplasma haemofelis

Wright-Giemsa stain; 100× oil objective
FIGURE 2 A peripheral blood smear obtained from a 7-year-old spayed domestic shorthair cat presented with marked macrocytic, hypochromic, and nonregenerative anemia (hematocrit, 11%; reference interval, 25%-46%). Many small (0.2 µm), blue-staining, ring- and rod-shaped organisms can be seen on the surface of the RBCs, characteristic of Mycoplasma haemofelis (arrows). Rarely, these organisms form small chains.
Hemotropic mycoplasmas are small bacteria that lack a cell wall and can infect the surface of erythrocytes.5 Identification of the organisms on a blood smear can be an insensitive method of detection, especially with chronic carriers.6 These organisms cannot be cultured in a laboratory.5 PCR-based testing is optimal for diagnosis of M haemofelis.5
Immunocompetent cats acutely infected with M haemofelis can experience severe hemolytic anemia, which is typically regenerative; however, nonregenerative anemia may occur.4 Chronically infected cats may be subclinical.
Sporothrix schenckii

Wright-Giemsa stain; 100× oil objective
FIGURE 3 A nasal swab cytology specimen from a 3.5-year-old spayed domestic shorthair cat presented with sneezing and mucopurulent nasal discharge. The specimen contained moderate mixed inflammation (neutrophilic and macrophagic). Rare, small (2-3 × 5-7 µm), oval- to cigar-shaped yeast structures with basophilic cytoplasm and a thin, nonstaining capsule can be observed extracellularly and, rarely, intracellularly within macrophages (arrows) and neutrophils, characteristic of Sporothrix schenckii.
Sporothrix spp are zoonotic, thermally dimorphic fungal pathogens that occur worldwide, particularly in tropical and subtropical climates. Infection in cats can occur via cutaneous inoculation or inhalation. Cytologic and histopathologic examination can provide a presumptive diagnosis, allowing initiation of antifungal treatment pending culture results. Fungal culture is optimal for diagnosis due to high sensitivity and specificity.7 Species classification can be determined via PCR.8
Cryptococcus neoformans

Romanowsky-type stain; 100× oil objective. Image courtesy of Basant Ahmed, The Ohio State University
FIGURE 4 An impression smear obtained from a draining tract on the nose of an FIV-positive, 3-year-old neutered male domestic shorthair cat presented with chronic progressive facial swelling with multiple draining tracts nonresponsive to antibiotic administration. Cytologic examination revealed moderate mixed (neutrophilic and macrophagic) inflammation. Numerous round-to-oval yeasts measure 7 to 20 µm in diameter. Yeasts have thick, nonstaining capsules and are arranged extracellularly (arrows) and, frequently, intracellularly within foamy macrophages (arrowhead). Occasional yeasts exhibit narrow-based budding and indicate Cryptococcus neoformans.
Cryptococcus spp are dimorphic basidiomycetous fungi and are the most common systemic fungal infection in cats.9,10 Most infected patients are not immunosuppressed, and infection likely primarily occurs via inhalation through the nasal cavity.9 Definitive diagnosis can usually be achieved with evaluation of cytologic specimens from affected tissues.9 Fungal culture requires several days for results but can provide helpful information (eg, species, drug susceptibility). Histopathology with special stains and immunohistochemistry can also aid in diagnosis.
Anaplasma phagocytophilum
Wright-Giemsa stain; 100× oil objective
FIGURE 5 A peripheral blood smear obtained from a 3-year-old neutered male Labrador retriever presented with fever, hyporexia, and peripheral lymphadenopathy. CBC revealed marked thrombocytopenia (44,000/μL; reference interval, 145,000-463,000/μL). The blood smear confirmed thrombocytopenia and showed the presence of frequent blue–gray intracytoplasmic morulae within neutrophils that were 3 to 5 µm in diameter and appeared as multiple punctate blue–gray coccobacilli arranged in spherical groups (arrow). A tick-borne disease PCR assay was positive for Anaplasma phagocytophilum.
A phagocytophilum is an obligate intracellular bacterium primarily transmitted by Ixodes spp ticks. The bacterium forms host-membrane–enclosed morulae in granulocytes, primarily neutrophils.11 These morulae cannot be differentiated from Ehrlichia ewingii morulae on a blood smear, and PCR is needed to distinguish between these tick-borne diseases in geographic areas where both can be found. Most patients infected with A phagocytophilum do not experience clinical signs.11 Infected dogs can develop mild to severe thrombocytopenia. Other cytopenias can occur; the underlying mechanisms of these cytopenias remain unclear.11
Compatible patient history, clinical signs, presence of morulae in peripheral blood granulocytes, positive serology, and positive PCR results for A phagocytophilum can help with definitive diagnosis.
Histoplasma capsulatum & Mycoplasma haemocanis in a Single Patient

Wright-Giemsa stain; 100× oil objective
FIGURE 6 A peripheral blood smear obtained from a 3-year-old spayed Yorkshire terrier presented with severe anemia and abdominal effusion. Rare monocytes and neutrophils containing small (1-2 µm), oval-shaped yeast structures with a thin, clear halo and a basophilic, eccentrically placed nucleus can be seen (arrow). Structures were morphologically compatible with Histoplasma spp. Similar yeasts were observed in the abdominal fluid cytology.
CBC revealed marked macrocytic, markedly regenerative anemia (hematocrit, 9%; reference interval, 36%-54%; absolute reticulocytes, 157,000/μL; reference interval, <60,000/μL), moderate thrombocytopenia (platelets, 81,400/μL; reference interval, 106,000-424,000/μL), and moderate leukocytosis (WBC, 38,500/μL; reference interval, 4,100-15,200/μL) characterized by a mature neutrophilia and mild left shift.
Histoplasma capsulatum is a dimorphic soil-borne fungus that occurs globally but is particularly endemic in the Mississippi and Ohio river valleys of the United States. Infection occurs via inhalation of microconidia from the environment.12 Cytologic examination of affected tissues can provide a presumptive diagnosis, allowing early initiation of treatment. Correlation of compatible clinical signs, other diagnostic testing results, and positive urine fungal antigen testing via quantitative enzyme immunoassay can help achieve a definitive diagnosis.12

Wright-Giemsa stain; 100× oil objective
FIGURE 7 Histoplasmosis has been associated with mild to severe nonregenerative anemia; however, this patient had a markedly regenerative anemia. Further evaluation of the blood smear revealed the presence of many small (0.1-0.3 µm), basophilic, epierythrocytic cocci forming long chains and occasional ring-shaped forms (arrows). These structures were compatible with Mycoplasma haemocanis, which was later confirmed with PCR.
M haemocanis is a small epierythrocytic bacterium that lacks a cell wall and can cause hemolytic anemia of variable severity.5 Rhipicephalus sanguineus is believed to be the main tick vector for infection.5 Blood smear examination can reveal the presence of M haemocanis on the surface of erythrocytes, but sensitivity is low. PCR-based testing is optimal for definitive diagnosis of M haemocanis infection.5
Dirofilaria immitis

Wright-Giemsa stain; 20× objective
FIGURE 8 A peripheral blood smear obtained from a 7-year-old neutered male American pit bull terrier presented for preoperative blood work. Rare microfilariae were present (arrow).
CBC results were within reference intervals. A heartworm antigen test was subsequently performed and was positive for Dirofilaria immitis.
Reviewing the blood smear is important, as shown in this case. Circulating D immitis microfilariae may be undetectable in up to 20% of positive dogs.13
Leishmania infantum

Wright-Giemsa stain; 100× oil objective
FIGURE 9 A submandibular lymph node aspirate obtained from a 5-year-old spayed crossbreed dog presented with periocular alopecia, blepharitis, and lymphadenopathy. Cytologic findings included lymphoid and plasma cell hyperplasia and a moderate increase in macrophages and neutrophils. Frequent small (2-5 µm), round-to-ovoid structures with basophilic nuclei and small rod-shaped kinetoplasts were noted extracellularly and within macrophages (arrow). Structures were morphologically compatible with Leishmania spp amastigotes.
The owner confirmed the dog had a travel history outside of the United States.
Canine leishmaniosis is a chronic protozoal infectious disease in which clinical signs can take 3 months to 7 years to develop.14 Infection can occur via bites from Phlebotomus spp and Lutzomyia spp sand flies, blood transfusion, sexual transmission, or vertical transmission.14 Diagnosis can be complex and includes a combination of clinicopathologic testing and specific diagnostics (eg, cytologic and/or histologic demonstration of the presence of Leishmania spp organisms, quantitative serology, PCR-based assays, culture).14
Canine Distemper Virus
Romanowsky-type quick stain; 100× oil objective
FIGURE 10 A peripheral blood smear obtained from a 5-month-old male crossbreed dog presented with fever, lethargy, cough, conjunctivitis, and diarrhea. Round, eosinophilic, variably sized (1-3 µm) cytoplasmic inclusions within neutrophils compatible with canine distemper virus (CDV) intracytoplasmic viral inclusions can be seen (arrows).
Vaccinations were not up to date. CDV was suspected based on history of exposure to a CDV-positive dog and an ELISA assay positive for the CDV antigen.
Cytoplasmic inclusions associated with CDV are common with acute infections, although detection on a blood smear is poorly sensitive overall. Viral inclusions may appear in erythrocytes, lymphocytes, and monocytes in peripheral blood and appear more prominent with the use of Romanowsky-type quick stains.15 Definitive diagnosis can be achieved with PCR-based assays.